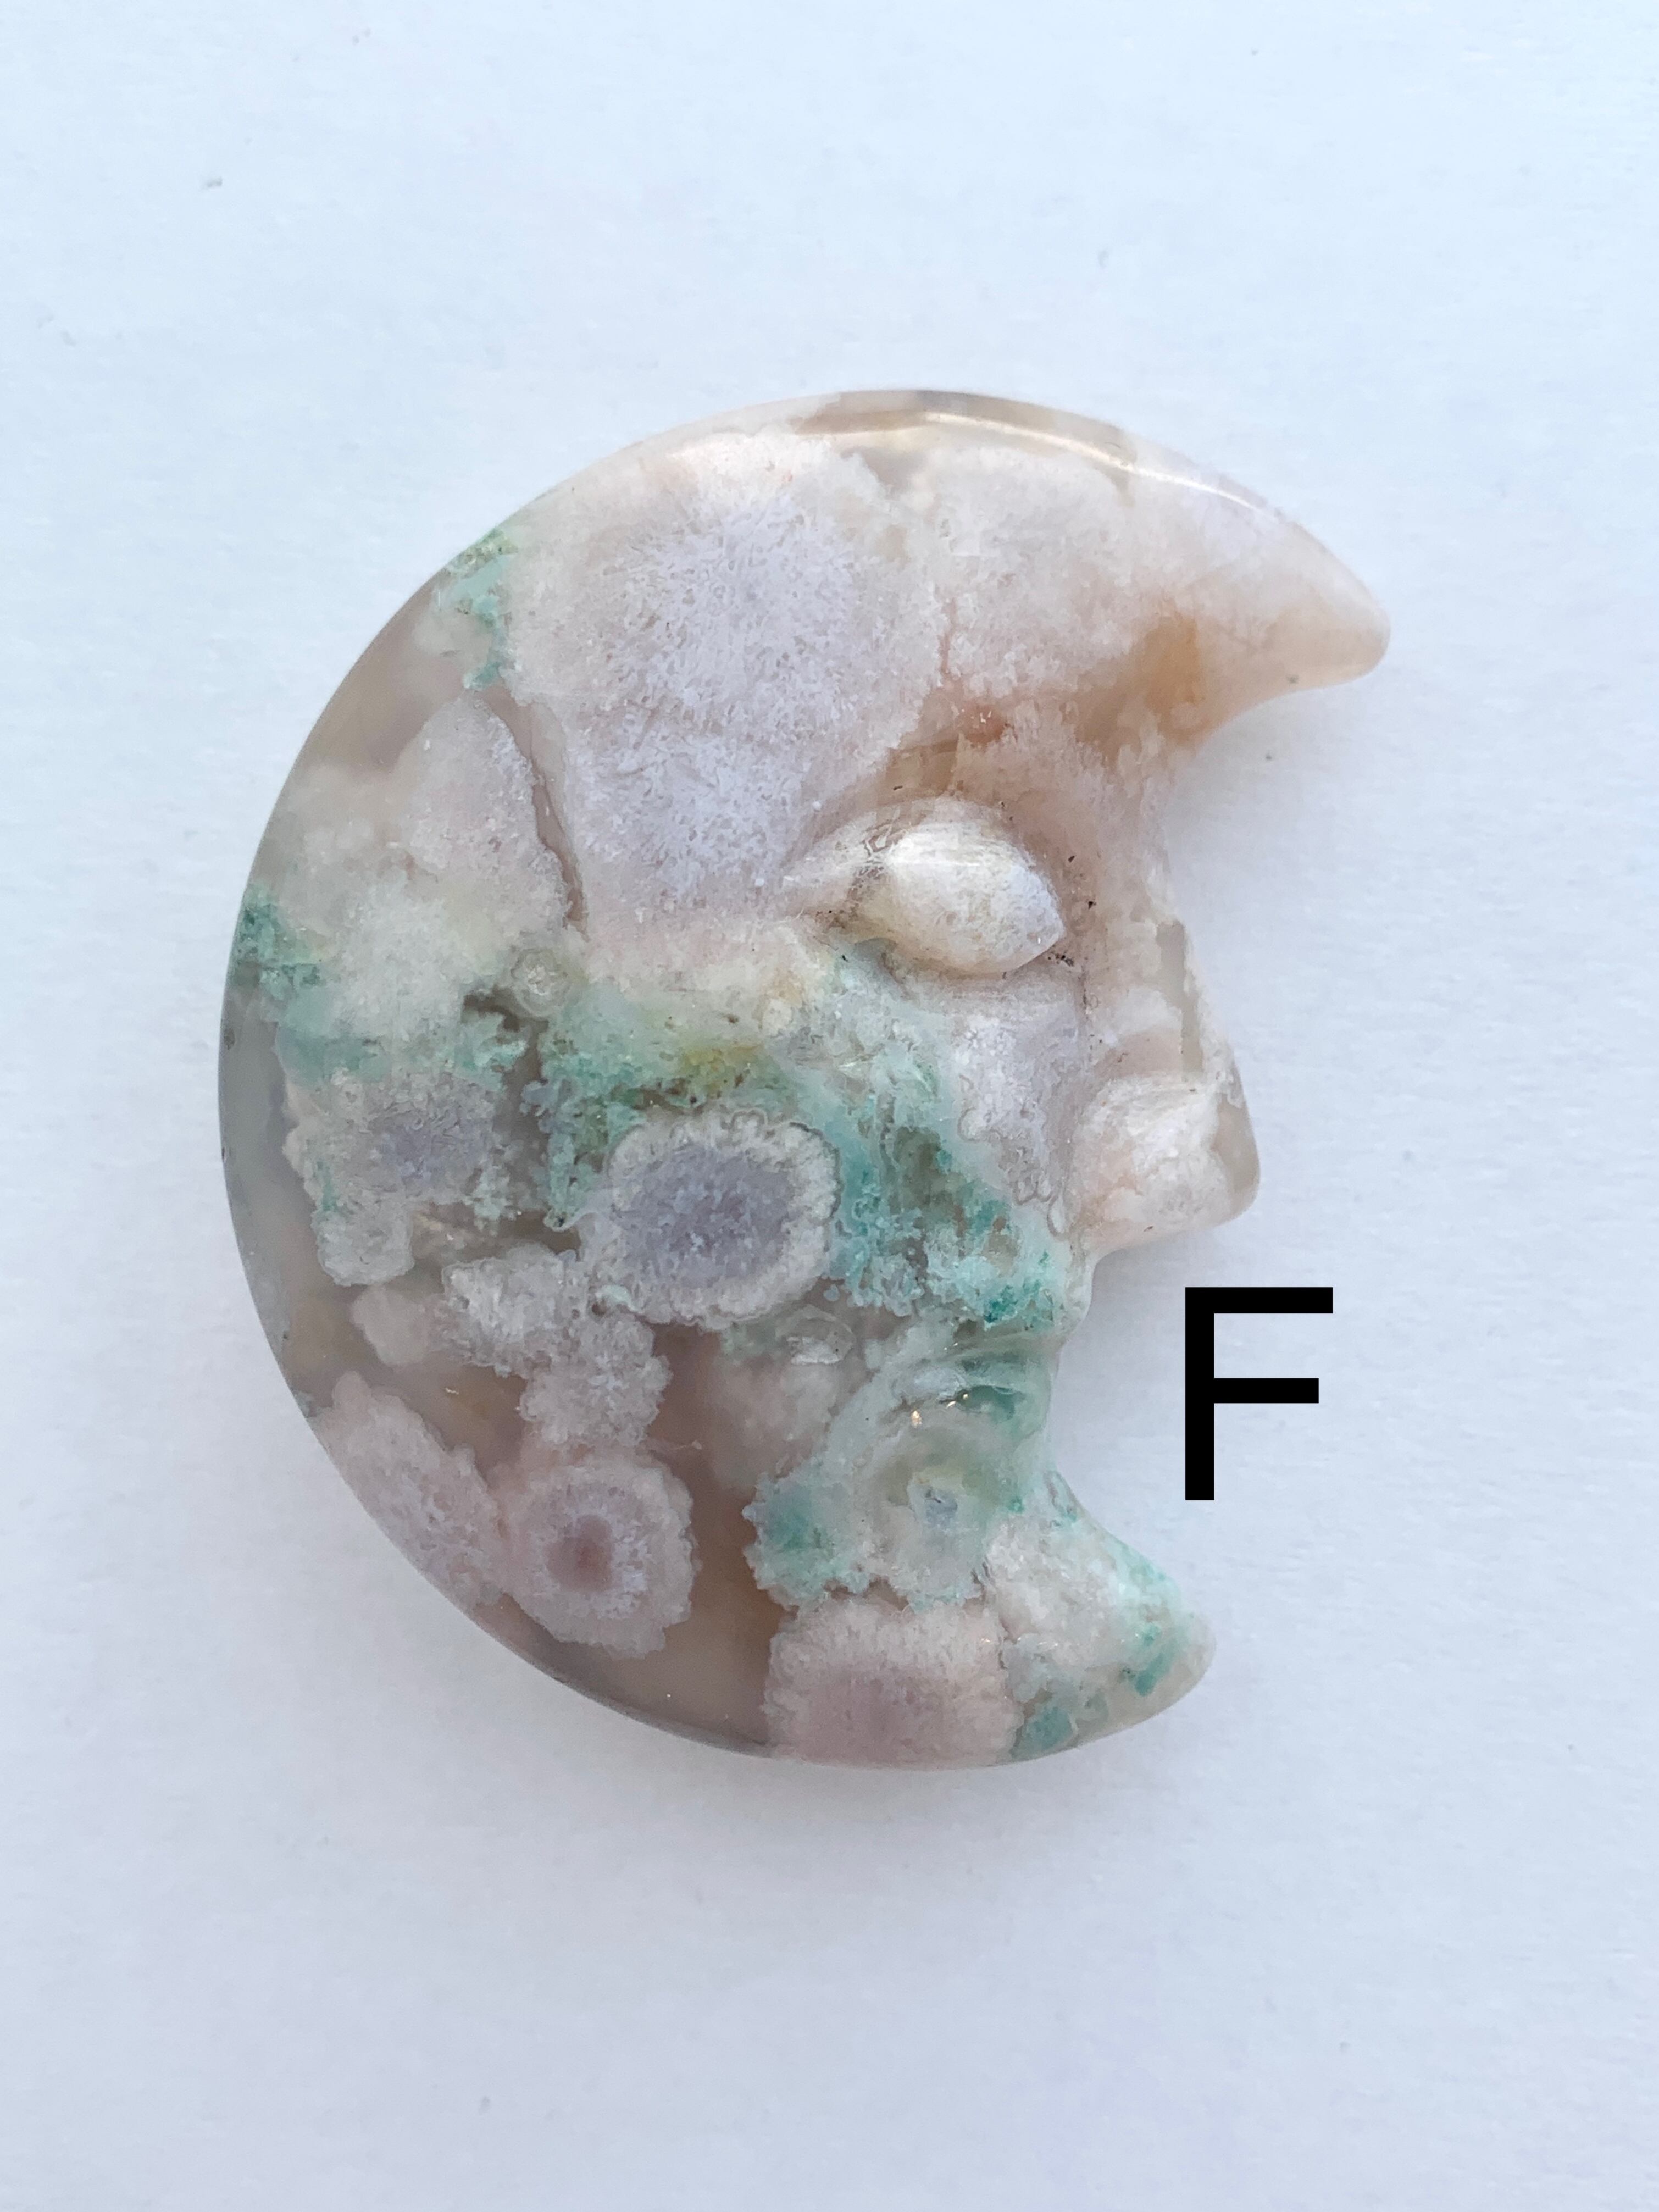

フラワーアゲートムーン
¥3,800
SOLD OUT
フラワーアゲートのドリーミーなムーンフェイスが入荷致しました。
A〜Fの6種類。
春の石と言えばフラワーアゲート、よく見るとハート型をしたフラワー結晶を持つピースも♪
様々な個性を持つフラワーアゲートはコレクターさんも多いストーン、お気に入りのピースを見つけて下さいね♪
◯Eの上部先端欠けておりますが、当たりが柔らかくなるよう研磨されております。
※ 研磨されているものでも小さなカケやクラックなどが入っております。石の特性上避けられないものですのでご理解の上ご購入をお願い致します。
Size
A 約5.7㎝×4.7㎝ 厚み約1.6㎝ 重さ約55g
B 約5.8㎝×4.8㎝ 厚み約1.6㎝ 重さ約57g
C 約5.3㎝×4.3㎝ 厚み約1.2㎝ 重さ約36g
D 約5.7㎝×4.5㎝ 厚み約1.1㎝ 重さ約40g
E 約5.5㎝×4.4㎝ 厚み約1.6㎝ 重さ約51g
F 約4.9㎝×3.9㎝ 厚み約1.6㎝ 重さ約38g
※ 必ずお読み下さいませ※
お手数ですが合わせてショップ規約もお読み下さいませ。
商品に欠陥がある場合を除き、サイズ感や色がイメージと違うなどのお客様都合による返品交換、ご注文後のキャンセルは対応致しかねます。
商品お写真は全ての箇所を掲載しきれない場合もございます。鉱物は内包物の色や表面のカラー、クラック、小さな穴や欠け等かが写りきらない場合もございます。海外研磨の石にはバラつきがございます。ポイントも先端が鋭利に尖りきっていないもの、研磨されたものであっても欠けがあるものもございます。天然石はぶつけたり落とした衝撃でも割れたり欠けてしまいます。お取り扱いには充分ご注意下さいませ。そういった天然石の特性をご理解ご了承頂けます方のみご購入をお願い致します。気になる箇所がございます場合はご購入前に必ずお問い合わせ下さいませ。天然石は直射日光や湿気などで退色、劣化しますので置き場所にはご注意下さい。お届け後の使用や保管による劣化や割れ、欠けなどは各自自己責任となります。一緒に撮影に使用している他の鉱物やアクセサリー、インテリアなどは付属致しません。
お使いのPCモニターや携帯によっては色の写りが違ってみえる事もございます。カラーが違ってみえたなどのお客様都合による返品は受け付けておりませんのでご了承下さいませ。
*********************
「Trésor de la paume 」mineral ・手のひらの宝物
目で楽しむ鉱物の世界。特に色や形など美しい鉱物にこだわって集めました。
どの鉱物も手のひらサイズでキラキラと輝く石、透き通った氷のような石、お菓子のような石と色々な表情をしています。
空間の浄化や鉱物の美しさをお楽しみ下さい。
-
レビュー
(0)